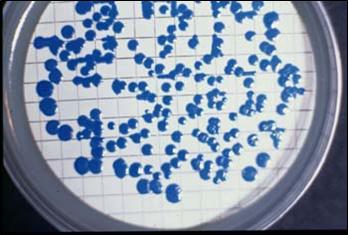
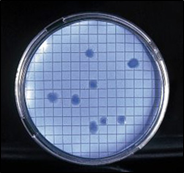

M-FC BROTH es el caldo MF para uso con cartón absorbente para enumerar coliformes fecales en aguas y otros líquidos
Enumeración selectiva y diferencial para de coliformes fecales por el método MF (UNE 77-063:1990)
COMPOSICIÓN
Triptosa 10.00 g
Extracto de levadura 3.00 g
Peptona prot.de carne 5.00 g
Sales biliares 1.50 g
Cloruro sódico 5.00 g
Lactosa 12.50 g
Azul de anilina 0.10 g
(Fórmula por litro)
pH final: 7.4 ± 0,2
PREPARACIÓN
Disolver 37 gramos de medio en 1 litro de agua bidestilada. No hace falta añadir ácido rosólico, EDTA ni TTC si las aguas no son residuales o tóxicas. No calentar. Esterilizar por filtración o bien hirviendo durante 5 minutos. ¡NO AUTOCLAVAR!. El color final del medio es azul claro. Proteger el medio preparado de la luz.
PROTEGER EL MEDIO DE LA LUZ O SU ASPECTO FINAL SERÁ INCOLORO, INÚTIL.
PARA USO EXCLUSIVO EN LABORATORATORIO.
AGITE EL BOTE ANTES DE USAR.
MANTENGA EL BOTE BIEN CERRADO EN LUGAR
SECO, FRESCO Y OSCURO.
PRECAUCIÓN: CONTIENE SALES BILIARES.
DESHIDRATADO CODIGO: DMT164
CONTROL DE CALIDAD DEL MEDIO
Realizado en nuestro laboratorio; es prudente repetirlo en su laboratorio siempre que varíen las condiciones (más de 3 meses sin usar, tras desinfectar laboratorio, tras conservar a alta Tª, cuando adquiere aspectos extraños aunque no haya llegado la fecha de caducidad teórica de la etiqueta,…)
DESHIDRATADO: Polvo grueso, Beige
PREPARADO: Estéril, Azul (púrpura si se añade
ácido rosólico)
CONTROL DE CRECIMIENTO 24-48 h a 44°C
aproximadamente:
- Escherichia coli MKTA 25922, Bueno, Colonias azules. Con respecto a PCA standarizado*, recuento 100 %, pero de forma selectiva.
- Salmonella abony MKTN 6017, Inhibido.
- Shigella flexneri MKTA 12022, Inhibido.
- Pseudomonas aeruginosa MKTN 10662, crece con colonias grises
- Enterococcus faecalis MKTA 29212, Inhibido.
* El que cumple con recuperación superior al 92-125% con respecto a cepas cuantitativas trazables a la cepa tipo.
PRESENTACIÓN: VIALES PARA FILTRACION
DE MEMBRANA (2 y 100ml), MEDIO DESHIDRATADO
Medio selectivo y diferencial para recuento de coliformes fecales por la técnica de Filtración de Membrana en aguas. Debe su selectividad a las sales biliares y a la temperatura de incubación (44,5 ºC).
SIEMBRA
Añadir 2 ml de medio a un cartón del método M.F. Depositar la membrana filtrada sobre el mismo. Incubar a 44.5 ºC aproximadamente, durante 24 horas.
INTERPRETACIÓN
Los coliformes fecales crecen con colonias azules. Otras enterobacterias pueden crecer, pero con colonias rosadas. Puede ahorrar la estufa a 45 ºC y obtener estos mismos colores diferenciales de E. coli (azul) y demás coliformes (rojo) mediante el medio Mug Plus Cfs. Broth (viales y viales pinchables, sólo existe deshidratado agarizado).
El usuario final es el único responsable de la eliminación de los microorganismos según la legislación medioambintal vigente. Autoclavar antes de desechar a la basura.
Si desea más información sobre nuestros M-FC BROTH rellene nuestro formulario de contacto http://www.medioscultivo.com/contacto . O si lo prefiere póngase en contacto con nosotros a través de nuestro correo electrónico microkit@microkit.es o por teléfono en el nº 91-897 46 16